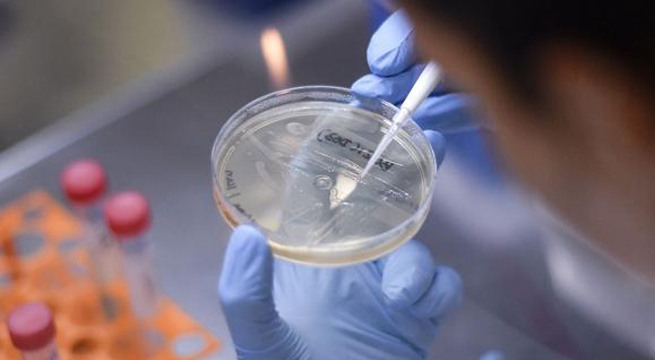
Variante india del Covid-19 es detectada en 10 países de América

El número real de fallecidos a causa de la enfermedad en el 2020 sería casi el doble de la cifra oficial

Las autoridades rusas informaron hace unas semanas que habían registrado la primera vacuna efectiva en animales
La Organización Panamericana de la Salud informó la presencia de la cepa denominada B.1.617 en nuestro continente

Esta nueva cepa ha sido identificada en el 80% de los pacientes analizados por el Instituto Nacional de Salud

Un estudio realizado en Argentina señaló una eficacia de 85,5% tras la primera dosis de la vacuna

El presidente estadounidense, Joe Biden, fijó un plazo hasta el 4 de julio para vacunar al 70% de adultos

En tanto, en julio se prevé empezar la vacunación del grupo correspondiente a 50 años a más.